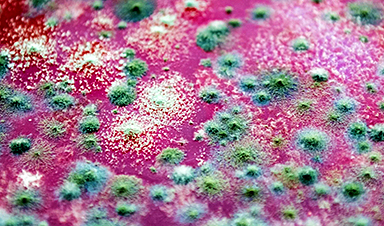

Scientists have uncovered a way to make existing antifungal drugs work again against deadly, drug-resistant fungi.
Fungal infections claim millions of lives worldwide each year, and current medical treatments are failing to keep pace. Scientists at McMaster University have now identified a molecule that could help address this growing problem. The compound, known as butyrolactol A, targets Cryptococcus neoformans, a fungus responsible for severe and often fatal disease.
Infections caused by Cryptococcus are especially dangerous. The organism can trigger pneumonia-like symptoms and is well known for its resistance to antifungal drugs. It most often affects people with compromised immune systems, including cancer patients and individuals living with HIV. Other fungi pose similar risks, including Candida auris and Aspergillus fumigatus, both of which have also been designated priority pathogens by the World Health Organization due to their threat to public health.
Despite the seriousness of these infections, treatment options remain extremely limited. Physicians currently rely on just three major classes of antifungal drugs.
Few Drugs, Serious Limitations
The most commonly used option is a group of medications known as amphotericin. Gerry Wright, a professor in McMaster’s Department of Biochemistry and Biomedical Sciences, notes that the drug’s effectiveness comes with significant drawbacks. He jokes that it is often referred to as “amphoterrible” because of the severe toxic side effects it can cause in patients.
“Fungal cells are a lot like human cells, so the drugs that hurt them tend to hurt us too,” he says. “That’s why there are so few options available to patients.”

The two remaining classes of antifungal drugs, azoles and echinocandins, offer far more limited protection, particularly when it comes to treating Cryptococcus infections. According to Wright, azoles only slow fungal growth instead of eliminating the organism. At the same time, Cryptococcus and several other fungi have developed complete resistance to echinocandins, leaving those drugs unable to stop the infection.
Because the development of new antifungal medicines has largely stalled, and existing treatments are losing their effectiveness, researchers are exploring alternative strategies. One promising approach involves the use of compounds known as “adjuvants,” which could help overcome resistance and strengthen the impact of current therapies.
“Adjuvants are helper molecules that don’t actually kill pathogens like drugs do, but instead make them extremely susceptible to existing medicine,” explains Wright, a member of the Michael G. DeGroote Institute for Infectious Disease Research (IIDR).
Turning to Adjuvants
Looking for adjuvants that might better sensitize Cryptococcus to existing antifungal drugs, Wright’s lab screened McMaster’s vast chemical collection for candidate molecules.
Quickly, his team found a hit: butyrolactol A, a known-but-previously-understudied molecule produced by certain Streptomyces bacteria. The researchers found that the molecule could synergize with echinocandin drugs to kill fungi that the drugs alone could not.
But they had no idea how it worked — and almost didn’t bother to find out.
“This molecule was first discovered in the early 1990s, and nobody has ever really looked at it since,” Wright says. “So, when it showed up in our screens, my first instinct was to walk away from it. I thought, ‘it’s a known compound, it kind of looks like amphotericin, it’s just another toxic molecule — not worth our time.’”
But he credits the determination of postdoctoral fellow Xuefei Chen for changing his mind.
“Early on, this molecule’s activity appeared to be quite good,” says Chen, who works in Wright’s lab. “I felt that if there was even a small chance that it could revive an entire class of antifungal medicine, we had to explore it.”
How the Adjuvant Works
After years of what Wright calls “painstaking sleuthing and detective work” led by Chen, the research team revealed exactly how the adjuvant worked.
Chen discovered that butyrolactol A acts as a plug that clogs up an important protein complex that’s “mission critical” for Cryptococcus — “when it’s jammed, all hell breaks loose,” Wright says. This disturbance renders the fungus completely vulnerable to the drugs that it once resisted.
Working with researchers in the laboratory of McMaster Professor Brian Coombes, also a member of the IIDR, the research team has since shown that butyrolactol A also functions similarly in Candida auris, which gives it broad clinical potential.
Wright says the findings, published recently in the prestigious journal Cell, are more than a decade in the making.
“That first screen that put butyrolactol A on our radar took place in 2014,” he notes. “More than eleven years later, thanks almost entirely to Chen, we have identified a legitimate drug candidate and an entirely new target to attack with other new drugs.”
Reference: “Butyrolactol A enhances caspofungin efficacy via flippase inhibition in drug-resistant fungi” by Xuefei Chen, H. Diessel Duan, Michael J. Hoy, Kalinka Koteva, Michaela Spitzer, Allison K. Guitor, Emily Puumala, Aline A. Fiebig, Guanggan Hu, Bonnie Yiu, Sommer Chou, Zhuyun Bian, Yeseul Choi, Amelia Bing Ya Guo, Wenliang Wang, Sheng Sun, Nicole Robbins, Anna Floyd Averette, Michael A. Cook, Ray Truant, Lesley T. MacNeil, Eric D. Brown, James W. Kronstad, Brian K. Coombes, Leah E. Cowen, Joseph Heitman, Huilin Li and Gerard D. Wright, 31 December 2025, Cell.
DOI: 10.1016/j.cell.2025.11.036
News
Stanford’s Revolutionary New Microscope Reveals Living Cells in Stunning Detail
Stanford researchers have developed a microscope that can show how nanostructures interact inside living cells at the highest resolution achieved so far. The view into living cells just got better. Stanford researchers have merged [...]
What Bundibugyo Ebola vaccines and treatments are under development
By Mariam Sunny and Jennifer Rigby May 29 (Reuters) – Global health authorities are racing to identify medical options to help contain an Ebola outbreak in eastern Democratic Republic of Congo, linked to the [...]
Why More People in Their 30s Are Suddenly Getting Colon Cancer
A major Swiss study found that colorectal cancer is becoming increasingly common in adults under 50, even as rates decline in older age groups. Researchers in Switzerland have identified a concerning trend: while colorectal [...]
Researchers Compare MS Models to Human Tissue in Search for Better Therapies
Researchers identified key differences between two widely used multiple sclerosis models, showing how each can better study myelin damage, immune responses, and repair. The findings may improve efforts to develop treatments that restore lost [...]
Scientists Discover Genetic “Off Switch” That Supercharges CAR T Cells Against Cancer
A new study reveals a possible way to make CAR T-cell therapy more durable and effective by targeting a single gene-regulating protein. CAR T-cell therapy is widely seen as a breakthrough in personalized cancer [...]
New Vitamin B12-Based Therapy Could Change How Brain Cancer Is Treated
Researchers have identified a vitamin B12–based compound that appears capable of crossing the blood–brain barrier and selectively accumulating in glioblastoma tissue. For decades, one of the biggest problems in brain cancer treatment has had [...]
Simple Fiber Supplement Cuts Knee Arthritis Pain in Just 6 Weeks, Study Finds
A daily inulin supplement may help reduce knee osteoarthritis pain while revealing a possible link between gut health, muscle function, and pain sensitivity. For millions of people living with knee osteoarthritis, managing chronic pain [...]
This Common Vitamin May Help Stop Prediabetes From Turning Into Diabetes
Vitamin D may help prevent type 2 diabetes in people with specific genetic variations, offering a possible path toward personalized diabetes prevention. More than 40% of U.S. adults have prediabetes, a condition in which [...]
Ebola, hantavirus: Is the world prepared for the next pandemic?
Funding cuts to health research and a growing antivaccine movement are making it harder than ever to respond to viruses. The World Health Organization (WHO) has declared that an Ebola outbreak in Uganda and [...]
May 2026 Healthcare News and Trends: Market Signals That Matter
Artificial intelligence is dominating headlines, telehealth has settled into a new normal, and digital health continues to promise transformation. However, much of what is being discussed in healthcare today reflects potential rather than reality. [...]
Scientists Rewire Donor Stem Cells To Outsmart Aggressive Blood Cancers
Researchers have tested a gene-edited stem cell transplant designed to shield healthy blood-forming cells from powerful cancer-targeting immunotherapies. For patients with highly aggressive blood cancers, stem cell transplantation can offer a rare chance at [...]
Recent Digital Health Trends, Insights and News – May 2026
Last month marked continued progress as digital health moves into its next phase — from AI expanding into drug discovery and core infrastructure to new federal pathways accelerating device access and home-based care. Together, [...]
Cancer Mystery Solved: Scientists Discover How Melanoma Becomes “Immortal”
Scientists have uncovered a previously overlooked mechanism that may help melanoma cells become effectively “immortal.” Cancer cells face a major problem before they can become deadly: They have to figure out how to stop [...]
How Visual Neurons Organize Thousands of Synaptic Inputs
Summary: A new study uncovered the organizational rules that determine how neurons in the primary visual cortex process information. By imaging both the cell bodies (soma) and the individual synapses (on dendritic spines) of [...]
Scientists Just Found a Surprising Way To Destroy “Forever Chemicals”
Scientists have uncovered a new mechanism that may help break down highly persistent PFAS pollutants. PFAS have earned the nickname “forever chemicals” for a reason. These industrial compounds are so chemically durable that they [...]
Scientists Discover Cheap Material That Kills Deadly Superbugs
A new sulfur-rich antimicrobial polymer shows strong effectiveness against fungal and bacterial pathogens and may offer an affordable solution to antimicrobial resistance. Antimicrobial resistance is creating growing challenges for both healthcare and food production, [...]